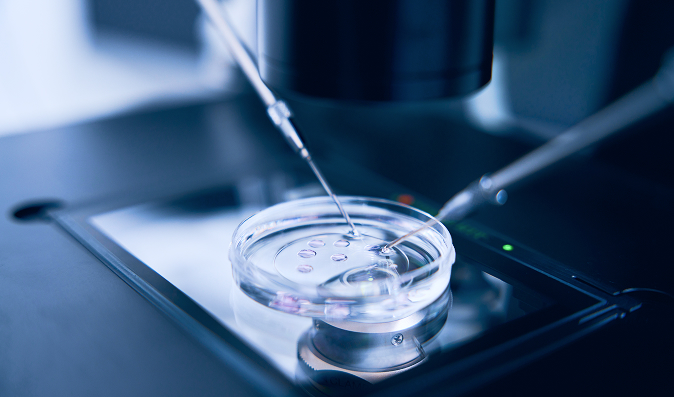

CIBERER Biobank
Avanzando en la investigación de enfermedades raras
Encuentra las muestras que necesitas para tu investigación
Accede al catálogo del CIBERER Biobank y localiza muestras biológicas de enfermedades raras, pacientes y familiares.
CIBERER Biobank
El CIBERER Biobank (CBK) es una plataforma nacional de apoyo a la investigación biomédica. Reunimos, conservamos y gestionamos muestras biológicas de personas afectadas por enfermedades raras, garantizando la calidad, la trazabilidad y el acceso ético para la comunidad científica.
Servicios para investigadores
El CIBERER Biobank ofrece una amplia gama de servicios diseñados para apoyar a grupos de investigación públicos y privados. Desde la cesión y procesamiento de muestras, hasta la gestión integral de información asociada, trabajamos bajo estrictos estándares de calidad y confidencialidad.
Cesión de muestras biológicas para investigación
Custodia y almacenamiento seguro
Procesamiento y preparación de muestras
Servicio de información y trazabilidad
Gestión y control de calidad
Tarifas
Donación de muestras
Tu contribución puede marcar la diferencia. Donar muestras al CIBERER Biobank permite a los investigadores disponer de material biológico de valor incalculable para avanzar en el conocimiento y tratamiento de las enfermedades raras.
